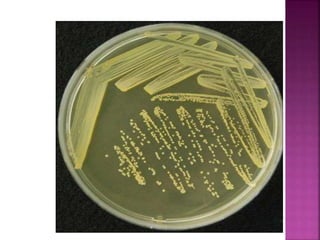
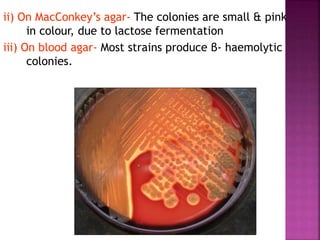
ii) On MacConkey’s agar- The colonies are small & pink
in colour, due to lactose fermentation
iii) On blood agar- Most strains produce β- haemolytic
colonies.

The document provides a comprehensive overview of Staphylococcus, detailing its history, classification, morphology, and biochemical characteristics. It highlights pathogenicity, resistance mechanisms, virulence factors, diseases caused, laboratory diagnosis, and treatment methods for infections like those from Staphylococcus aureus and related species. Emphasis is placed on antibiotic resistance, particularly methicillin-resistant Staphylococcus aureus (MRSA), and the importance of appropriate diagnostic techniques in managing these infections.

![ Conventional identification methods for
MRSA detection including disk diffusion
method with oxacillin, latex agglutination
test and oxacillin-salt agar screening test
and etc.
According to the recommendation of
Clinical and Laboratory Standards
Institute (CLSI), disk diffusion method
with cefoxitin [27] was applied on MRSA
detection massively.](https://image.slidesharecdn.com/staphylococcus123-200404153245/85/Staphylococcus-54-320.jpg)
![ Bacterial inoculum of each sample strain is made and adjusting
the turbidity to 0.5 McFarland.
One drop of this suspension was inoculated on Mueller–Hinton
agar containing NaCl (40 g/L) and oxacillin (6 μg/mL) [32].
Plates are incubated at 35 °C for 24 h then.
Observed by naked eye, any strains growth on the plate
containing oxacillin should be recognized as MRSA.
The sensitivity is 100% when screened by this method [33].
In oxacillin screen agar test, several different strains can be
cultivated and tested on one plate..](https://image.slidesharecdn.com/staphylococcus123-200404153245/85/Staphylococcus-55-320.jpg)
![ A simple and rapid method, MRSA screen
latex agglutination assay for the detection of
methicillin resistance using a specific
monoclonal antibody directed toward the
PBP2a antigen has been developed [38]
Aimed at membrane protein extraction,
monoclonal antibody reacts and then
produces macroscopic particle aggregate to
identify MRSA.
Also, some other latex reagents react with
PBP2a existing in cell membrane.](https://image.slidesharecdn.com/staphylococcus123-200404153245/85/Staphylococcus-56-320.jpg)



